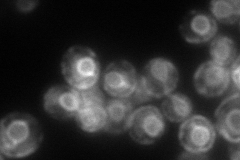
YML128C
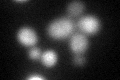
YML128C
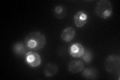
YML128C

View description
Protein of unknown function; mutant is defective in directing meiotic recombination events to homologous chromatids; the authentic, non-tagged protein is detected in highly purified mitochondria and is phosphorylated
Localization:
Intensity:
Fold change:
Significance:
-
C’ GFP library in SD

ER28.91 -
N' NOP1pr-GFP in SD

ER,vacuole127.153 -
N' TEF2pr-mCherry in SD
ER139.444 -
N' NATIVEpr-GFP in SD

missing0 -
N' TEF2pr-VC and Cyto-VN in SD

#N/A0 -
C’ GFP library in SD+DTT
ER46.261.59Yes -
C’ GFP library in SD+H2O2

ER39.271.35Yes -
C’ GFP library in Starvation Media
ER112.763.89Yes -
C’ GFP library on the background of Pup2-DaMP

ER -
C’ GFP library on the background of CCT mutant

ER41.45821.4338Yes
